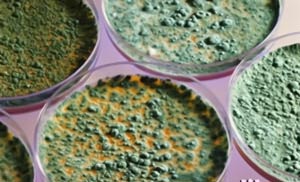

Allergia penész
A gombák a legnagyobb csoportot az élőlények természetes módon előforduló szinte bárhol, bármilyen éghajlat, bármikor az évben.
Hogy nem lép kapcsolatba velük lehetetlen. Ma már tudjuk, 80 000 gombafaj ellen, de úgy vélik, hogy ez csak 10% -át teszi ki a számot.
Mold - egy gomba, hogy a nő a meleg és nedves környezetben egyaránt az otthonunkban, és azon kívül. Érdemes megjegyezni, hogy ez egy erős allergén, felelős sok esetben súlyos asztma (az egyik leggyakoribb típusú allergia). Habitat feltételek modern házak egyre hozzájárulnak ehhez a folyamathoz. De, sajnos, ez a gomba még kevéssé ismert. Ismeretes, hogy általában, ebben a formában kereszt-allergiák közötti atkák, pollen vagy élelmiszer.
Allergia ellentmondásos elkülönített formák, amelyek belépnek a szervezetbe légzés, mert könnyen légi úton szállított. Sokan közülük a mérete 2-10 mikron, és vannak bizonyos típusú viták kevesebb, mint két mikron. Ezek nehéz megölni, mert azok könnyen áthaladnak a szűrőkön és a maszkok.
Penész telepszik bármilyen párás helyen - a szobanövények és virágcserepeket, nedves falak, ablakok, tapéta, matracok, ágyak, pincék, padlások, uszodák, üvegházak és a fürdőszoba. Ha a helyiség (főleg a földszinten), nyirkos falak, hogy úgy tűnik, fehéres vagy zöldes foltok, elérve a padlót. Ez nem más, mint egy ültetvény penész.
Fűtés bután gáz és párásító tovább bonyolítja a kérdést, mert növeli a páratartalmat a haza, és hozzájárulnak a megjelenése kondenzációs zóna, ami a legjobb feltételeket penész szaporodás.
Mould leülepszik mind a természetes és szintetikus anyagok. 20 ° C-on és 80% nedvességtartalom mellett tartva ez jól növekszik. Ezért egyének által okozott asztma gombaspórák, rosszabbul, ha meleg és párás, és ősszel, amikor a lebontott levelek lehullanak a fákról. Ha ezeket az időszakokat az ember rosszul érzi magát, akkor az allergén, a legvalószínűbb, a penész.
Penész megjelenhet a gyümölcsök, zöldségek, gabonafélék, élesztő, sajt, bors, savanyú káposzta és szárított gyümölcsök, valamint a szeszes italok, mint a bor vagy a sör. Nem valószínű, hogy valaki megeszik az almát, ami látható penész, de vannak olyan kultúrák, amelyek láthatóak csak mikroszkóp alatt, és allergiát okozhatnak. Ha néhány gyümölcs és zöldség jelenik meg magát, akkor lehet, hogy csak egy allergia a penész, hanem az élelmiszer-intolerancia.
Ez vonatkozik a penicillin, ami szintén egy gomba, és a személy jelenlétében allergiás gombák, a legvalószínűbb, hogy lesz ezt a gyógyszert.
Hogyan lehet megszabadulni a penész a házban
Nem számít, mennyire eltúlzott úgy tűnhet, de az allergiás tünetek jelentősen gyengül, ha a megfelelő intézkedéseket, hogy csökkentse a páratartalom fogadható el. Ezért, mint már említettük, az egyetlen módja annak, hogy megszüntesse a gomba az épületben - a párásodás zóna és fenntartása az alacsony nedvességtartalom. Ahhoz, hogy ezt a jól kell szellőztetni házban, vagy telepíteni egy légkondicionáló berendezés a hőszivattyú (hideg vagy meleg levegőt). Segíti és párátlanító, amely lehet telepíteni a hálószobában a nap folyamán, és éjszaka - a közös szobában és a konyhában. De minden esetben, ezek az intézkedések elősegítik csak részben, ha nem szünteti meg a forrás a nedvesség. Szükséges, hogy megszüntessék a víz szivárog és nedvesség falak.
Vannak speciális módon tudják kezelni penész a falakon, az első emeleten. Az egyik ilyen módszer pumpálnak a falak, a speciális folyékony töltet a pórusokat, a tégla és obstruktív nedvességet a talaj fel. Ezt a folyadékot fecskendeznek a pórusokat, a fal minden fél méter, néhány hónappal később a falak kiszáradnak és a penész eltűnik.
Ezen túlmenően, kereskedelmi forgalomban rendelkezésre álló hatóanyagok, amelyek elpusztítják a penész. Meg kell figyelmesen olvassa el, mi van írva a címkén, hiszen erős vegyi anyagok, amelyek reakcióba. A kezelés után a felületek kell tisztítani a halott penész, mert provokál allergia újra. Megölni a penész, akkor más folyadékok, mint például az alkohol vagy szeszesital, de nem keverjük össze őket. Kedvenc helyek település a penész - fém ablakok, fürdőszoba, konyha, gumi tömítés a hűtőszekrény ajtaját, és a fagyasztó és a légkondicionáló, kivéve a pincék, falak és a nedves elemeket. De ha nem oldja meg a problémát a nedvesség szükséges penész az élet, akkor újra ugyanazon a helyen, amint ott kap egy új vitát.
Nem szabad hígítani a házban szobanövények, mert a penész megjelenhet a levelek és a földön. Meg kell alaposan mossa gyümölcsöt és zöldséget, és vigye a bőrt, mint lehetséges.
Nem ajánlott vásárolni iparcikk enzimeket tartalmazó penész. Nehéz meghatározni, hogy mely termékek tartalmaznak enzimeket penész, mivel a gyártó nem köteles jelezni ezt a címkén (meg lehet tanulni közvetlenül tőle). De még mindig jobb, hogy egy erőteljesebb megoldás kiválasztása természetes szappan és a gyenge fogpor helyett paszta, amely kiküszöböli a felesleges kockázatot.
Meg kell szabadulni a bútorok illata a penész, mert fertőzött meg. A ruhák, függönyök, szaglás penész, akkor is jelen van, ezért kell őket akár alaposan meg kell tisztítani, vagy helyébe másik.
Ne feledje, hogy megszabadulni a penész nem lehetséges, de a monitoring hőmérséklet, páratartalom és a lehetséges kondenzációs területeken segít javítani az egészségre.
Ez veszélyes Alternaria
A spórák a gomba gyakran okoznak az asztma. Ez a leggyakoribb gomba, hogy a nő a szabadban. Ő él a lehullott levelek, pusztuló növények és szerves anyag, és a spórái lebegnek a levegőben. A házak úgy rendezi az ablakkeretek - helyezi páralecsapódás.
Alternaria spórák kiemeli az év minden napján, de legfőképpen a forró és párás napokban. Jelenlétük az otthonokban köszönhetően a magas koncentráció a belépő levegő az ablakon át, míg az aránya összege közötti külső és belső megközelítőleg 4-1.
Alternaria okoz allergiás rhinitis, kötőhártya-gyulladás és az asztma akár tüdőgyulladást érzékeny ember. Ez egy nagyon erős allergén okozhat asztmás beteg a halál. Tény, hogy ezek a viták egyik fő oka a gyermekkori asztma és az emberek, állandóan érintkezésben Alternaria nedves területeken, ahol sok szerves anyag (rétek, gyümölcsösök, konyhakertek).
Tünetei allergia gomba leggyakrabban jelennek meg késő tavasszal és ősszel.